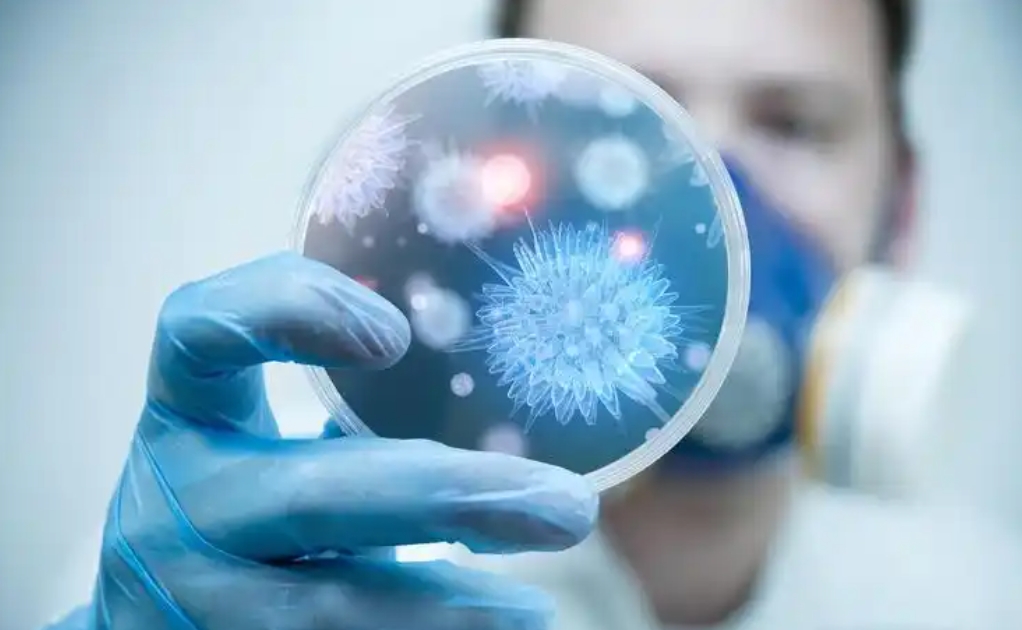

供精试管婴儿面向的患者群体绝大部分都是单身,未婚或者是男方患有死精症等,在深圳有不少机构都是支持开展供精试管婴儿治疗,不过都是私立的机构,公立机构有8家,但是目前都不支持供精试管婴儿,有这方面需求的建议考虑私人机构,下面小编为大家汇总了深圳地区供精做试管的机构名单,一起来看看吧。
深圳供精试管机构名单汇总
深圳目前共有8家机构是或者开展辅助生殖技术资质的,但是只能够提供常规的辅助生殖治疗,不包含供精试管婴儿,有需求的可以考虑韶关市妇幼保健院、汕头大学医学院第一附属医院、广东省妇幼保健院这几家,下面是深圳试管婴儿机构名单汇总:

序号 |
医院 |
科室 |
准入技术 |
1 |
北京大学深圳医院 |
生殖中心 |
夫精/一代/二代/三代试管 |
2 |
香港大学深圳医院 |
生殖中心 |
夫精/一代/二代试管 |
3 |
深圳中山泌尿外科医院 |
生殖中心 |
夫精/一代/二代试管 |
4 |
深圳市妇幼保健院 |
生殖中心 |
夫精/一代/二代/三代试管 |
5 |
深圳市人民医院 |
生殖中心 |
夫精/一代/二代试管 |
6 |
深圳恒生医院 |
生殖中心 |
夫精/一代/二代试管 |
7 |
深圳市第二人民医 |
生殖中心 |
夫精人工授精技术 |
注:上述表格内容仅提供参考,具体请以实际为准。
深圳目前只有俩家机构是支持第
三代试管婴儿治疗的,很多不孕不育的患者夫妇都选择在深圳进行试管婴儿的治疗,但是目前深圳是没有公立机构支持做供精试管婴儿的,有需求的建议寻找私立机构,或者通过本文直接咨询来了解。